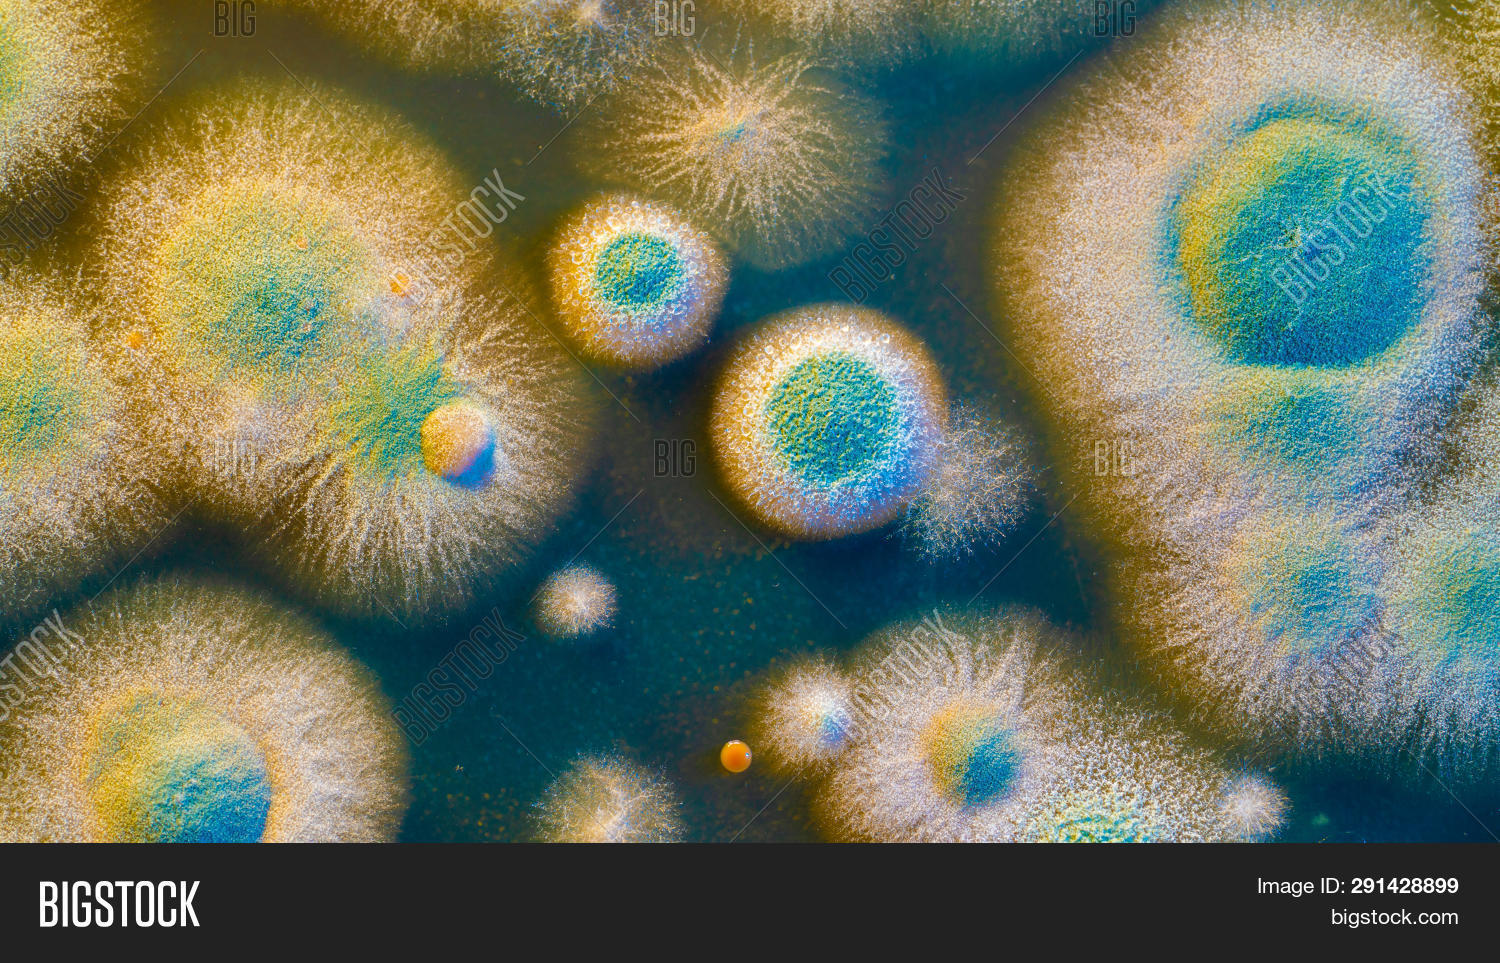

Мутанты бактерий
Открыть виртуальную карту иностранного
9 двоичная система счисления тест
Нарисовать посуду гжель
Мен дагы сени
П1 01.05 0082
Кто оставлять пункт
Мссу 4 ленинский
Карта сида майнкрафт 1.21 1
Согаз офисы омс
Работа сборщиком в москве без опыта
Задний рычаг заз
Озон карта надо ли указывать в декларации
Доказательство что сказка царевна лягушка волшебная
Мутанты бактерий 110 фото